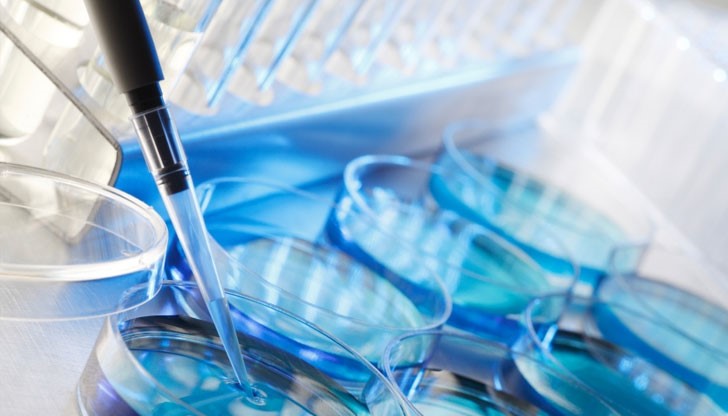
Бави се извършването на инвитро при двойките у нас с репродуктивни проблеми, които са били одобрени от държавата за безплатни процедури Бави се извършването на инвитро при двойките у нас с репродуктивни проблеми, които са били одобрени от държавата за безплатни процедури

Чиновници препънаха инвитрото
- Редактор: Симона Георгиева
- Коментари: 0
Бави се извършването на инвитро при двойките у нас с репродуктивни проблеми, които са били одобрени от държавата за безплатни процедури.
Причината е, че през 2013 г. финансирането на Фонда за асистирана репродукция, който подпомага семействата, беше прехвърлено от здравното министерство към НЗОК. Там обаче работата по изплащането на парите за инвитро е забуксувала.
Въпреки че година по-късно фондът отново е прехвърлен към здравното ведомство, вече има забавяне с около осем месеца. Толкова чакат двойките, одобрени по документи, реално да започне процедурата им, обясни пред „Труд“ Стефка Сарафова-Захариева, председател на сдружение „Зачатие”, което е сред съоснователите на центъра за асистирана репродукция.
В момента във фонда работят петима служители, които успоредно с новите заповеди за инвитро се занимават и с изплащането на старите. Забавянето се компенсира с по 1-2 месеца на година, или са нужни между 4 и 8 години, за да няма чакане повече.
Фондът работи добре, като бюджетът му тази година е увеличен с 2 млн. лв. спрямо 2015-а и вече е 12 млн. лв., уточниха пред вестника от фондация „Искам бебе“, друг негов съосновател. Към 2015-а над 145 000 двойки в България са имали проблеми да заченат. От над 30 хил. семейства, кандидатствали за 7 г. за инвитро, само няколко не са одобрени.
























BMW се размаза на булевард „Липник“
BMW се размаза на булевард „Липник“
BMW се размаза на булевард „Липник“
Повреден светофар предизвика катастрофа в Русе
BMW се размаза на булевард „Липник“